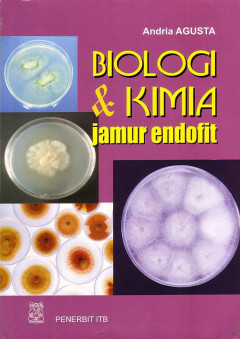

Hasil Pencarian
Ditemukan 285 dari pencarian Anda melalui kata kunci: callnumber=5
Permintaan membutuhkan 0.00694 detik untuk selesai
Informasi
Akses Katalog Publik Daring - Gunakan fasilitas pencarian untuk mempercepat penemuan data katalog
Akses Katalog Publik Daring - Gunakan fasilitas pencarian untuk mempercepat penemuan data katalog